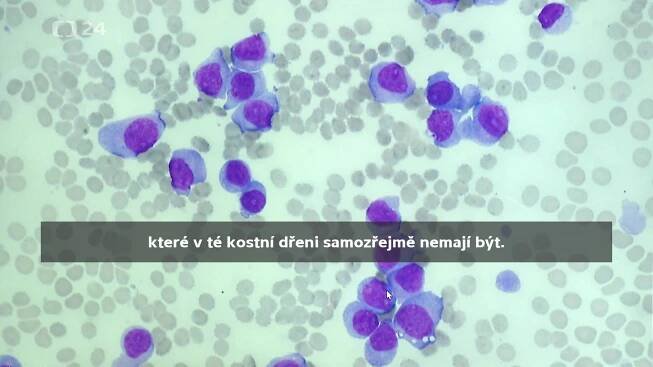

Leukemie›Medikamenty užívané k léčbě
Isotretinoin
Chemická sloučenina
Methotrexát
Chemická sloučenina
Rituximab
Chemická sloučenina
Dasatinib monohydrate
Chemická sloučenina
Ibrutinib
Chemická sloučenina
Ruxolitinib
Chemická sloučenina
Bosutinib
Chemická sloučenina
Imatinib
Chemická sloučenina
Pipobroman
Chemická sloučenina
Doxorubicin hydrochloride
Chemická sloučenina
Nilotinib
Chemická sloučenina
Irinotekan
Chemická sloučenina
Vincristine
Chemická sloučenina
Cytarabin
Chemická sloučenina
Leukémie je léčitelné onemocnění. Léčba zahrnuje chemoterapii, ozařování nebo hormonální terapii. Její úspěšnost závisí na typu leukémie i na věku pacienta. U dětí je šance na trvalé vyléčení vyšší než u dospělých pacientů. I v případě, že nemoc nelze zcela vyléčit, přináší léčba naději na prodloužení…
Videa›Leukémie léčba
Dětská leukémie
19. 9. 2021
Léčba leukémie
31. 1. 2014
Efektivnější léčba leukémie
31. 1. 2014
Léčba chronické lymfocytární leukémie
Před měsícem
Leukémie - Příznaky typy a léčba
Leukémie je nádorové onemocnění vycházející z buněk kostní dřeně, nebo lymfatického systému. Postihuje bílé krvinky ...
Akutní leukemie: léčba | NZIP
Akutní leukemie jsou závažná onemocnění, která se mohou v krátké době stát život ohrožujícími, pokud nejsou léčena. Proto je nutné co nejrychleji zahájit vhodnou ...
Leukémie – typy, příčiny, příznaky a léčba | EUC.cz | EUC
Leukémie je závažné nádorové onemocnění krvetvorby. Nejdůležitějším faktorem pro úspěšnou léčbu je včasná diagnostika nemoci .
Co je leukémie?
Leukémie je zhoubné nádorové onemocnění krvetvorby, které se vyznačuje zmnožením bílých krvinek, které jsou nezralé a neplní svou normální funkci. Tyto krvinky se vyskytují v kostní dřeni, v krvi a někdy také v dalších orgánech. Forma i úspěšnost léčby se odvíjí od konkrétního typu leukémie, celkového zdravotního stavu pacienta i stádia nemoci.Jak leukémie ovlivňuje tvorbu krve?
U leukémie dochází k poruše krvetvorby, kdy kmenové buňky začnou produkovat velké množství jednoho typu krvinek, který však nedostatečně vyzrává. Takové krvinky pak neplní svou funkci, postupně vyplňují kostní dřeň a jsou vyplavovány do krve. Leukemické buňky se mohou shromažďovat v různých orgánech. Kostní dřeň už nezvládá tvořit dostatek normálních krvinek a rovnováha krvetvorby je porušena.Jak funguje chemoterapie a jaké jsou její vedlejší účinky?
Chemoterapie je léčba formou tablet či nitrožilně za pomocí cytostatik, která zastavují buněčný růst. Léčivo se dostává do krevního oběhu a likviduje nádorové buňky. Působí však i na jiné rychle se množící buňky lidského těla, proto je nezbytné je užívat velmi zodpovědně a podle pokynů lékaře. Vedlejší účinky chemoterapie se u jednotlivých pacientů mohou velmi lišit svou intenzitou, většinou mezi ně patří výrazný dočasný útlum normální krvetvorby, nevolnost, zvracení, nechutenství, zánět sliznic a dočasná ztráta vlasů.Leukemie – Wikipedie
Leukemie (nebo také leukémie, [1 ] [2 ] řecky leukos λευκός, „bílý“ a haima αίμα, „krev“, odtud i starší český termín bělokrevnost), zastarale též hemoblastózy, představují nádorová onemocnění, která vycházejí z krvetvorné tkáně a z…
odkazuje na služby nejen od Seznam.cz.
© 1996–2025 Seznam.cz, a.s.